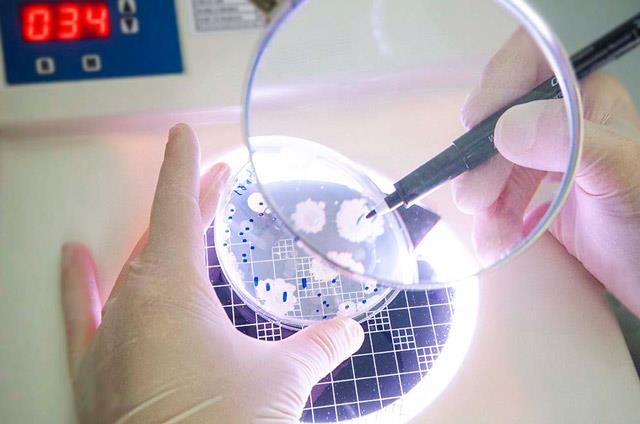
4-Gen m�hendisli�i: 5 y�l i�inde genomlar �zerinde �al��malar 7 kat artt�

2019'A Damga Vuracak 19 Yeni Teknoloji
Amerika Birleşik Devletleri merkezli teknoloji danışmanlık şirketi Lux Research, 2019 yılına damga vurması beklenen 19 dijital teknolojiyi sıraladı.
-

Amerika Birleşik Devletleri (ABD) merkezli teknoloji danışmanlık şirketi Lux Research, 2019 yılına damga vurması beklenen 19 dijital teknolojiyi sıraladı.Uzay teknolojilerinden sağlığa, arttırılmış gerçeklikten gıda teknolojilerine; dünyayı dönüştürme potansiyeline sahip teknolojileri açıklayan firmanın araştırmasının tepesinde yapay zeka yer alıyor. Listenin ilk beşi şöyle sıralanıyor:
-

1-Yapay zeka ve makine öğrenimi: Son bir yıl içinde 10 bin zeka patenti başvurusu yapıldı
-

2-Giyilebilir teknolojiler: Risk sermayesi ile sektöre son 5 yılda toplam 2 milyar dolar aktarıldı
-

3-Boyutlu yazıcılar: Sektörde patent alımları 2014 yılından bu yana yüzde 60 arttı
-

4-Gen mühendisliği: 5 yıl içinde genomlar üzerinde çalışmalar 7 kat arttı
-

5-Arttırılmış gerçeklik (AR) ve sanal gerçeklik (VR): Risk sermayesi her yıl 2 milyar dolar aktarıyor.
-

LİSTEYE GİREN YENİ TEKNOLOJİLER 19 teknoloji arasında, araştırmanın 'yeni' olarak işaret ettiği, yani 2018 yılı listesine dahil olmayan ancak önümüzdeki 12 ay boyunca özellikle izlemeye değer bulunan teknolojilerin bazıları ise şunlar:
-

6-Hızlı akü şarj teknolojisi: Listedeki yer alan birçok 'temiz' enerji teknolojisinden biri, elektrikli araç pazarının büyümesinde kilit bir faktör olarak kabul ediliyor.
-

9-Grafen ve 2D malzemeler: Basılabilir elektronik mürekkepler, kompozit malzemeler, fosil yakıt hücrelerinde kullanılan elektrotlar, lityum-iyon piller ve süperkondansatörler gibi diğer teknolojilerin gelişmesini sağlayacak.
-

10-Dronlar: Güvenlikten hava haritalamasına kadar çeşitli alanlarda artan bir rol oynayan dronların daha fütüristik uygulamaları arasında zirai hastalıkların tanımlanması, denizaltı boru hatlarının bakımı ve çevresel gözleme bulunuyor.
-

11-Hassas tıp: Belirli problemleri hedef alan ve bireyler için kişiselleştirilmiş ilaçların gelişimi.
-

12-Perovskit kullanılan güneş panelleri: Güneş panellerini daha verimli hale getirme potansiyeline sahip olan perovskit teknolojisi, son yıllarda çok konuşulmasa da 2019'da bu alanda büyük gelişmeler bekleniyor.
-

16-Doğal dil işleme: Bilgisayarların insan dilini anlamalarına, yorumlamalarına ve manipüle etmelerine yardımcı olan yapay zeka dalı. Örneğin, Siri, Alexa ve diğer sanal asistanlar kullanıcılarla etkileşim kurararak kullanımın kolaylaştırmasını sağlar.
-

17-Üretken tasarım: Ürün tasarımındaki tüm olası seçenekleri göz önünde bulundurarak, "doğanın evrimsel tasarıma yaklaşımını taklit etmek" için yapay zeka kullanır.
-

18-Adrese teslim hizmetleri : Eve teslim sektöründe hangi araçların daha uygun olduğu artışması hala açık (seçenekler arasında bisikletler, motorlu bisikletler, scooterlar var, tabii hepsi kesinlikle elektrikle çalışıyor).
-

19-Blockchain: Para transferini kolaylaştırdığı için yeniden rüzgarı arkasına alabilir.
-

Listede bulunan diğer alanlar ise mikrobiyom, solid-state aküler, Iot güvenlik (internete bağlı cihazlar ve ağların güvenliği), 5G ağlar ve malzeme teknolojileri olarak sıralandı.